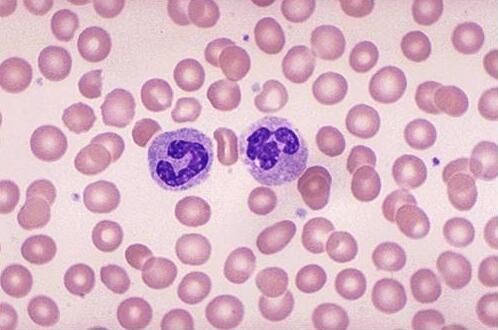
体育平台

我们都知道,癌细胞诡计多端,能够通过癌症干细胞的休眠来实现癌症复发,或是通过循环肿瘤干细胞来实现癌症扩散,当然它们还会利用机体免疫系统中的多个免疫细胞来实现其增殖扩散的目的;本文中小编就盘点了多篇重磅级研究来阐明癌细胞如何利用免疫细胞来进行癌症转移、增殖和扩散的。
【1】Science子刊:抵御机体感染的中性粒细胞或是帮助癌症扩散的“同谋”
DOI: 10.1126/scitranslmed.aag1711
当我们将机体免疫系统视为不可或缺的盟友时,机体抵御外来入侵者的第一道防线,包括可以“杀死”我们的防御机制或许就会肆意发展,然而在特定情况下,癌细胞就会扭转局面让我们的盟友成为敌人。近日,一项刊登在国际杂志Science Translational Medicine上的研究报告中,来自冷泉港实验室的研究人员就通过研究发现,机体中常见的白细胞—中性白细胞或许会被癌细胞“劫持”从而帮助癌症进行扩散,相关研究或为科学家们开发新型疗法来抑制癌细胞这种“劫持”行为提供一定帮助。
文章中,研究者Mikala Egeblad及其同事利用活体成像技术对三阴性乳腺癌小鼠模型进行研究,他们发现,中性白细胞能够衍生出一种新型的“武器”来帮助癌细胞在小鼠机体中扩散。癌细胞所利用的这种名为网格DNA的武器是从活化的中性粒细胞中分泌出来的,当中性粒细胞检测到威胁时就会释放此类物质,中性粒细胞释放的胞外菌陷阱(NETs)能够在细胞外部形成密集的蜘蛛网状结构,而形成这种网状结构脊柱的DNA上布满了毒性酶类,这些酶类能够降解并且消化外来入侵者。

【2】Nature:中性粒细胞——乳腺癌肺转移的重要“帮凶”
doi:10.1038/nature16140
尽管科学家们已经在癌细胞靶向药物开发方面取得显著进展,但治疗转移性肿瘤的治疗方法通常不是特别有效。许多研究表明癌细胞对它们所处的微环境存在依赖性,因此靶向肿瘤中的非癌细胞组成成分可能是新型治疗方法开发的重要基础。但是人们对于肿瘤生长和转移过程中宿主应答所发挥的作用仍了解较少,限制了新型治疗方法的开发。
在一项发表在国际学术期刊Nature上的最新研究中,来自英国弗朗西斯克里克研究所的研究人员发现中性粒细胞是乳腺癌小鼠模型肺转移灶微环境中的一种主要组成成分,同时也是促进转移灶形成的一个重要推动因素。
早期研究已经证明中性粒细胞在炎症性应答过程中发挥重要作用,但关于中性粒细胞是否会促进肿瘤形成一直存在争议。
【3】Oncogene:肿瘤细胞招募中性粒细胞驱动肺转移
doi:10.1038/onc.2012.201
肾细胞癌(renal cell carcinoma)是成年人原发性肾肿瘤中最常见的类型,占肾肿瘤的70~80%,占肾恶性肿瘤的90%。多见于60岁左右的人群,男性多于女性。初诊时肿瘤限于肾内的患者,术后五年生存率可达70%以上,但侵及肾静脉或扩散至肾周围脂肪组织的患者,五年生存率仅5~20%。
肾细胞癌(RCC)定向转移至肺组织的具体机制至今仍然知之甚少。为了研究分析转移过程中的具体分子机制,López-Lago MA等研究人员将不同肺转移潜能的人源肾细胞种植到小鼠体内。基因表达分析显示不同转移性细胞转移至小鼠肺间质与中性粒细胞特异性侵润有关。相关研究论文发表在Oncogene杂志上。
分析表明,肿瘤细胞株转移活性与趋化因子的数量包括CXCL5和IL - 8水平呈负相关。去除这些细胞株中的CXCL5和IL - 8,使我们能够将肺组织中中性粒细胞的浸润与癌细胞转移活性的趋化因子的分泌联系起来。

【4】Cancer Immunol Res:中性粒细胞或可介导口腔癌的转移
doi:10.1158/2326-6066.CIR-15-0017
近日,刊登在国际杂志Cancer Immunology Research上的一篇研究论文中,来自多伦多大学的研究人员通过研究发现,一种异常的免疫反应或反馈回路或许是口腔癌发生转移的原因,文章中研究者揭开了一系列特殊的免疫细胞—中性粒细胞和口腔癌发生转移扩散之间的明显关联。
研究者在文章中表示,细胞炎性和癌症发生之间存在千丝万缕的关系,而口腔癌患者机体存在特殊的炎性反应,口腔是在机体中非常特殊,在口腔中可以同时发生多种事件。研究者重点对中性粒细胞进行研究,中性粒细胞是口腔和唾液中非常常见的免疫细胞,但很多研究并没有将中性粒细胞和癌症拉上关系;并不像其它免疫细胞,中性粒细胞可以分泌很多分子,包括可以调节机体对炎性反应的肿瘤坏死因子a(TNFa)。
这项研究中研究者发现,口腔癌细胞可以分泌IL8,其作为另一种炎性介导子,可以激活中性粒细胞,随后有效地建立大规模的免疫反应或反馈回路;这种免疫反应回路或许会导致癌细胞侵入性结构的增加,而癌细胞恰恰可以利用这种结构来进行侵袭和癌症的扩散。如果可以揭示免疫系统同癌症相互作用的分子机制,那么研究者就可以通过调节免疫反应来获得抗癌效应,这样就可以代替促癌的作用了。
【5】PLoS ONE:首次发现白细胞和癌细胞融合可使癌症扩散
doi:10.1371/journal.pone.0066731
近日,来自耶鲁大学癌症研究中心的研究者同科罗拉多大学的研究者共同研究发现,当白细胞和癌细胞共同融合形成一种遗传杂交体时就会导致人类机体转移性肿瘤的发生,相关研究成果刊登于国际杂志PLoS ONE上,该项研究成果或许可以回答癌细胞为何会从最初的肿瘤发生位点转移到其它远距离的机体组织中去的。
在一个多世纪以前这样的理论首次被提出来用以解释癌症的转移,但是截止到现在这种理论在人类癌症中还没有被证实,因为同一病人细胞间的基因组差异非常明显,为了解决这个问题,文中研究者所研究的对象为黑色素瘤脑转移患者,患者患者接受了其兄弟的骨髓移植,研究者对这种患者机体中的二次恶性肿瘤的基因组DNA进行了深入分析。
【6】Nature:癌细胞与免疫系统玩躲猫猫游戏
doi:10.1038/nature18945
作为一个快速发展的领域,癌症免疫疗法旨在开发让人体自己的免疫系统抵抗癌症的技术。有多种可能的原因能够阻止T细胞识别癌细胞。首先,T细胞的活性受到很多能够干扰它们功能的抑制因素的控制,而且让这些抑制因素失效的疗法如今正在很多人类癌症中开展测试。其次,在一些病人体内,免疫系统可能并不会在第一时间将癌细胞作为异常细胞加以识别。
当免疫系统攻击癌症时,肿瘤进行自我修饰(包括DNA修饰)从而逃避免疫反应。肿瘤细胞在进行DNA修饰后会产生新抗原(neoantigen)。识别新抗原很可能是人们在临床上开发T细胞检查点阻断和过继性T细胞疗法等癌症免疫疗法的主要驱动力。因此,选择性地增强T细胞对新抗原识别能力的策略当前正在持续开发中。
【7】Hepatology:CXCL5介导中性粒细胞浸润促进肝癌转移
doi:10.1002/hep.25907
趋化因子是能使细胞发生趋化运动的小分子细胞因子,分子量多在8-14kDa之间。趋化因子与趋化因子受体结合后传递多种细胞信息。CXCL5是一个小分子类型的分泌蛋白,属于趋型趋化因子家族成员。近来,CXCL5与癌症发生发展的相关证据已经有很多。
最近,为了研究CXCL5在肝细胞癌的生长、侵袭和预后中的作用,研究人员研究了具有不同转移性能的人肝癌细胞系以及919例肝癌患者中CXCL5的mRNA和蛋白水平。
结果发现在高转移人肝癌细胞系中,CXCL5表达水平增加,与对照组相比,复发性肝癌患者的肿瘤组织中,CXCL5表达水平也增加。
CXCL5 激活肝癌细胞的PI3K-AKT和ERK1/2信号通路,促进肿瘤增殖、迁移和侵袭。此外,在体外研究中,CXCL5对中性粒细胞有直接趋化作用。在动物实验中,肝癌细胞中CXCL5的上调促进肿瘤细胞的生长以及肺转移,瘤内中性粒细胞浸润数目也增加。

【8】Cell:免疫细胞“起内讧”或促进胰腺癌恶化
doi:10.1016/j.cell.2016.07.046
日前一项刊登于国际杂志Cell上的一项研究报告中,来自纽约大学医学中心的研究人员通过研究发现,不同类型细胞间的内部冲突或可帮助解释为何免疫系统会奋力识别并且攻击胰腺癌,而遏制这场内讧或许就可以开发出潜在有效的胰腺癌新型疗法。
文章中研究者描述了一种名为“γδT细胞”的特殊类型的免疫细胞,他们发现这类免疫细胞可以帮助抑制其它抵御肿瘤的T细胞进入到胰腺肿瘤内部,如果没有γδT细胞的干预,CD4和CD8细胞就会不断增值并且主动攻击肿瘤,但不幸的是,免疫系统能够产生大量的促肿瘤γδT细胞深入到肿瘤中,并且干扰免疫细胞对肿瘤的攻击。
免疫疗法近年来取得了巨大的进步,即激活患者自身的免疫系统来抵御癌症,从而增强CD4或CD8细胞的活性,本文研究则表明,这种免疫疗法或许就可以靶向应用于胰腺癌的治疗中,除非γδT细胞被阻断,不然CD4和CD8细胞就不能正常发挥功能去遏制癌症发展。研究者George Miller博士指出,标准的免疫疗法或许对胰腺癌并不奏效,尤其是致死性的胰腺癌,如今我们获取了更多信息来解释其原因,机体主要的抗肿瘤防御机制或许在胰腺癌面前完全没有作用。

【9】PNAS:“神奇”抗体将癌细胞变为杀伤性免疫细胞使其自相残杀
doi: 10.1073/pnas.1519079112
近日,来自美国斯克利普斯研究所的研究人员发现一种将白血病细胞变成杀伤性免疫细胞的新方法。这一重大发现将促进白血病以及其他癌症治疗新方法的开发。相关研究结果即将发表在国际学术期刊PNAS上。
研究人员表示:"这是一种全新的癌症治疗方法,我们将尽快在病人身上进行进一步验证。"
该研究团队一直在建立和筛选大规模抗体库方面进行探索,旨在利用大规模筛选的方法找到能够结合特定靶向目标或激活特定受体的治疗抗体。在过去几年中,他们已经成功发现了一些能够激活骨髓细胞受体的抗体药物,这些抗体能够激活未成熟骨髓细胞的生长因子受体,诱导它们形成特定血细胞类型。
在最近的研究过程中,研究人员发现其中一些抗体还存在一些令他们意想不到的作用,这些抗体能够引起未成熟骨髓细胞变成一些完全不同的细胞类型,比如神经细胞。
研究人员表示,虽然其中的原因仍不清楚,但这一发现让他们对于能否将癌变骨髓细胞(白血病细胞)变为非癌变细胞产生了兴趣。
来源:生物谷
链接://news.bioon.com/article/6691881.html


![]() 蜀ICP备10000600号
蜀ICP备10000600号

